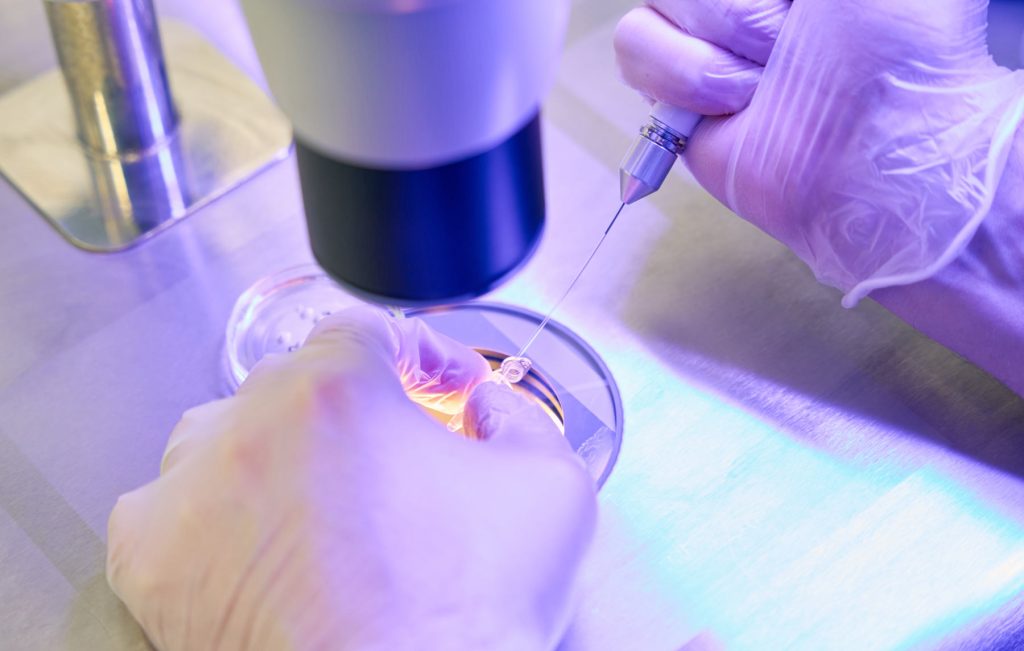
Male fertility tests

- About
Our consultants
Meet our experienced team of consultantsSupport team
Meet our support team working alongside our doctors to deliver the very best careOur clinic
Discover more about The Fertility & Gynaecology Academy
- Patient journey
I am a...
Learn about the services relevant to your fertility journeyThe journey...
Learn about what's involved in fertility treatment
- Fertility tests
Packages
Fertility testing packages to take the hassle out of investigations
More screening options
Find out about our additional screening options - Treatments
Getting pregnant
Fertility treatments to help you achieve your dream
Add-on treatments
Learn about add-on fertility treatments
Supporting treatments
Additional services to support you on your fertility journey - Success rates
- Knowledge hub
Watch, read, and learn
Expand your knowledge on all aspects of fertility - Pricing
Financing fertility treatment
Honest and transparent pricing for peace of mind
No two patients have the exact same treatment but here we have provided an example patient journey to help illustrate what a straight-forward IVF cycle might look like cost-wise.
- Contact
Male fertility tests
Whether you’re just starting on your journey or have been trying for a while, we’ve got you.
Choose from our male fertility test packages for peace of mind about your fertility.

Whether you’re just starting on your journey or have been trying for a while, we’ve got you.
Choose from our male fertility test packages for peace of mind about your fertility.
For a single fee, you’ll get a comprehensive assessment of your fertility potential, and we’ll guide you on the next steps in your journey.

Male fertility test packages
Below you’ll find details of our male fertility test packages. All tests are also available individually. If you have any questions, please don’t hesitate to get in touch.
Male fertility test package – level 1
-
Detailed semen analysis
-
Consultation with embryologist
-
Written report for semen analysis with a conclusion and advice
Male fertility test package – level 2
-
Detailed semen analysis
-
Sperm DNA fragmentation test
-
Consultation with fertility doctor
-
Written report for semen analysis with a conclusion and advice
Male fertility test package – level 3
-
Oxidative stress in semen (Reactive oxygen species in semen)
-
Sperm DNA fragmentation test
-
Consultation with fertility doctor
Male fertility test package – level 4
-
Sperm aneuploidy
-
Sperm DNA fragmentation test
-
Consultation with fertility doctor
Scroll down to get more details on each aspect of our fertility test packages for men.
Understanding fertility tests
Here, we explain the different elements of our male fertility test packages so you know what to expect.
If you choose a fertility test package with an initial consultation, this will be with one of our esteemed fertility specialists. We’ll explain to you the series of tests, throughout which you’ll have an expert consultant as your port of call.
At The Fertility & Gynaecology Academy we offer detailed semen analysis by a embryologist.
Please note: Semen analysis is performed by appointment at The Fertility & Gynaecology Academy and should be carried out at least 48 hours and not more than five days after the last ejaculation.
We test for:
- Sperm count – measures the amount of sperm per millimetre. A low sperm count means less chance of fertilising an egg.
- Sperm motility – assesses the movement of sperm. Normal motility is considered 40% or more.
- Sperm morphology – the shape of the sperm. Abnormal sperm can be caused by infection, smoking, heat, and prescribed and recreational drugs.
- Antisperm antibodies – produced by the immune system in response to a trauma or inflammatory processes. These antibodies are picked up by the MAR test and can indicate a cause of secondary infertility.
Sperm DNA fragmentation is a type of test carried out on a semen sample. A special dye is used to help ascertain if there is any damaged DNA in the sperm. DNA sperm fragmentation has been associated with many risks including difficulty conceiving, impaired embryo development and higher miscarriage rates. The good news is that with appropriate treatment it is possible to improve the sperm quality.
Oxidative stress is a phenomenon that occurs in the body as a result of an imbalance between antioxidants and reactive oxygen species. Oxidative stress is a cause of cell DNA damage which can cause abnormalities in the sperm including morphology and motility, in turn making it difficult to conceive. Oxidative stress can be exacerbated by lifestyle factors such as toxins in the environment, infections and even diet.
The sperm aneuploidy test allows us to evaluate sperm for the presence of an abnormal number of chromosomes. This test may be carried out if your partner has experienced miscarriage(s) of unknown origin or if previous IVF cycles have been unsuccessful.
Chosen a fertility test package that includes a consultation to explain the results of your fertility tests? We take the time to ensure that you are well-informed and fully understand the implications of any test results. You will have the opportunity to ask any questions and receive comprehensive answers in plain English so you’re never kept in the dark.
Semen analysis: A report will be provided which will have a detailed written breakdown of all our findings and recommendations so you are informed about your fertility status. Our experts are among the best in their field, and you can rest assured you’ll leave with advice you can trust. Having a report in writing also enables you and your partner to revisit this detailed information as many times as you need to, as you consider your options should further investigations be required.
All other tests: A copy of your results will be provided.

Getting help for fertility problems
If we find any abnormalities with your test results, there are plenty of treatments available to overcome these issues, including ICSI, PICSI (an add-on treatment), and surgical sperm aspiration.
Please note: HFEA view on PICSI. You can also find further information on the British Fertility Society website.
Please download our ‘Add-on Treatments Patient Information Leaflet’ below for evidence and associated risks.
Get in touch today
Here at The Fertility & Gynaecology Academy, we offer the gold standard in testing and treatment, to help you start the family you’ve always dreamed of.
Call us now on 020 7224 1880 to arrange for fertility testing, or book a consultation online.


